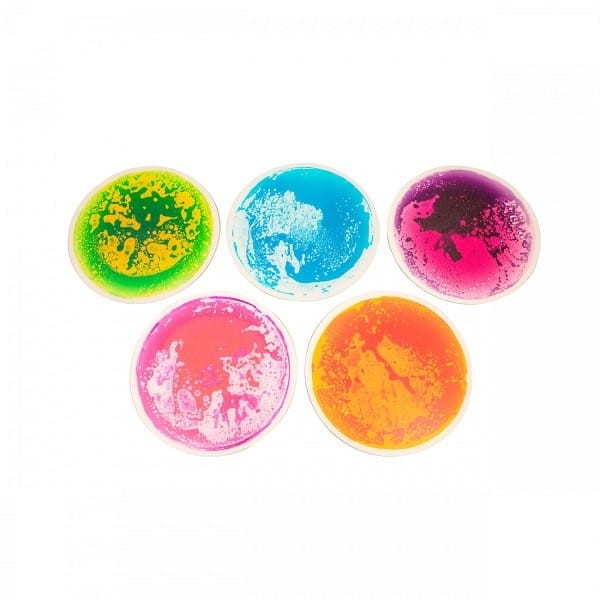
Sensoryczne płytki podłogowe okrągłe 50cm

Sensoryczne płytki podłogowe okrągłe 50cm
Kod produktu: AY-438317
Wystaw opinię o produkcie
Ceny podane bez kosztów dostawy.
Ceny podane bez kosztów dostawy.
Opis
Kolorowe podłogowe płytki sensoryczne okrągłe 50cm
Zalety podłogowych płytek sensorycznych:
- wykonane z wytrzymałych, bezpiecznych materiałów
- ciekawe kolory
- antypoślizgowa podstawa
- 5 płytek w zestawie, każda w innym kolorze
- wymiar: fi 50cm
Opinie
Jeśli dodałeś/-aś recenzję, a nie pojawiłą się na liście, być może oczekuje na moderację.
Wystaw opinię o produkcie
Dyrektywa GPSR
Producent
AMAYA SPORT S.L.
Pol.Ind.Talluntxe C/A Naves 12 a 20
31110 NOAIN, Hiszpania